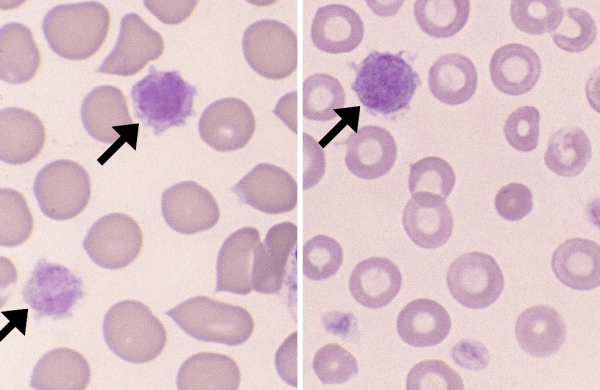
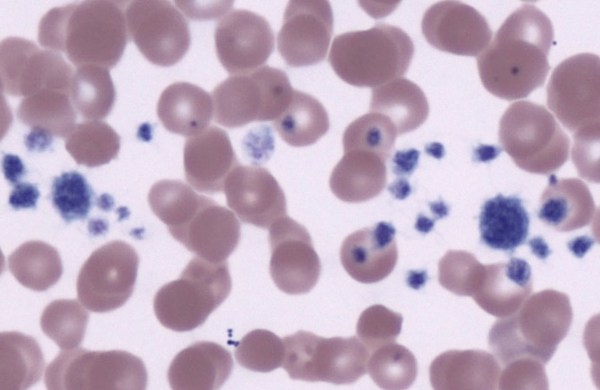

Morphology: clusters of numerous platelets. Platelets in clumps may be granulated (non-activated) or degranulated (activated). Look alike: clumps of degranulated platelets must be differentiated from strands of fibrin. Platelet clumps may be embedded… Read more Platelet Clumps →

Also called: macroplatelet Morphology: very large platelets (larger than red blood cells). Morphology may be normal or abnormal depending on underlying cause. Clinical relevance: giant platelets are often (but not always) immature… Read more Giant Platelet →

Morphology: platelets are small anucleate cells with round to oval shape and small pink or red cytoplasmic granules. Normal platelets are smaller than red blood cells. Canine platelets are moderately… Read more Normal Platelets →